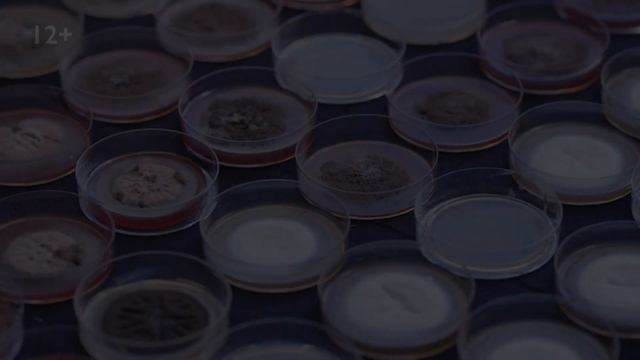
КРАСКА СПРЯТАЛА ШЕДЕВР?! АНТИСЕПТИК ДЛЯ КАРТИНЫ! | Наука Просто смотреть онлайн

Автор: Нейроинтеллектуальное сознание Страница 3

Прикольные видео с веселыми картинками №2

что хотите конец или начало (Я краснею мультфильм 2022)

нейросеть и крипта попытка 2

La Dalle - Thérapie (Clip Officiel)

Нейросеть учится выживать с использованием окружения

Новый телеграм бот помогает с переводом видео без искусственного интеллекта

How to Create your Custom Avatar ?
КРАСКА СПРЯТАЛА ШЕДЕВР?! АНТИСЕПТИК ДЛЯ КАРТИНЫ! | Наука Просто

17 Общая химия Основные понятия и законы химии Термохимические реакции Задача №5

Ramil' - Сияй | Vocal | Music text & beat |

С,А. в вопросах физики, философии в мировоззрении одного из нас. Аристократа Анатолия Горского

Around a topic - Prezi Template

E76

Заставка канала Карусель

OpenAI, ChatGPT'nin patronu Sam Altman'ı Neden Kovdu?

3 Best Text to AI Image Generator App Android

Tome 16: EXISTENCE Cosmetics & Overview! | Dead By Daylight New Skins, Charms & Cosmetics!

Вот это любовь! Просто хит! Русская Лана Дель Рей!

Adobe Animate урок №10 Анимацию формы

Реши задачу и заработай 1000 рублей: логическая задача про 14 монет (Задача решена)

Каша, как у дипинса????

How to Use Bard - Use Google Bard AI with this Quick Tutorial

Константин Довлатов Метафорические карты

Соловьёв В.А. Полёты в космос. Лекция 5.
За каждым успешным каналом стоит личность, идея и сотни часов кропотливого труда. Если вы здесь, значит, автор «Нейроинтеллектуальное сознание» уже сумел зацепить ваше внимание своим уникальным стилем или подачей. А мы на RUVIDEO позаботились о том, чтобы вы могли изучить весь архив его работ в максимально комфортных условиях — без лишней суеты и преград.
Почему за работами канала «Нейроинтеллектуальное сознание» так интересно наблюдать? Всё просто: это честный контент, который находит отклик в сердцах зрителей. На нашем ресурсе вы можете смотреть онлайн все видео любимого автора бесплатно и в хорошем качестве. Нам важно, чтобы вы видели каждую деталь и слышали каждый нюанс, поэтому мы используем только стабильные плееры из открытых источников Rutube.
Следите за новинками канала, пересматривайте старые шедевры и открывайте для себя новые грани творчества «Нейроинтеллектуальное сознание». Мы постоянно обновляем ленту, чтобы у вас под рукой всегда были самые свежие выпуски. Никаких сложных регистраций — только вы и творчество, которое вдохновляет. Приятного вам путешествия по миру авторского контента на RUVIDEO!
Видео взято из открытых источников Rutube. Если вы правообладатель, обратитесь к первоисточнику.